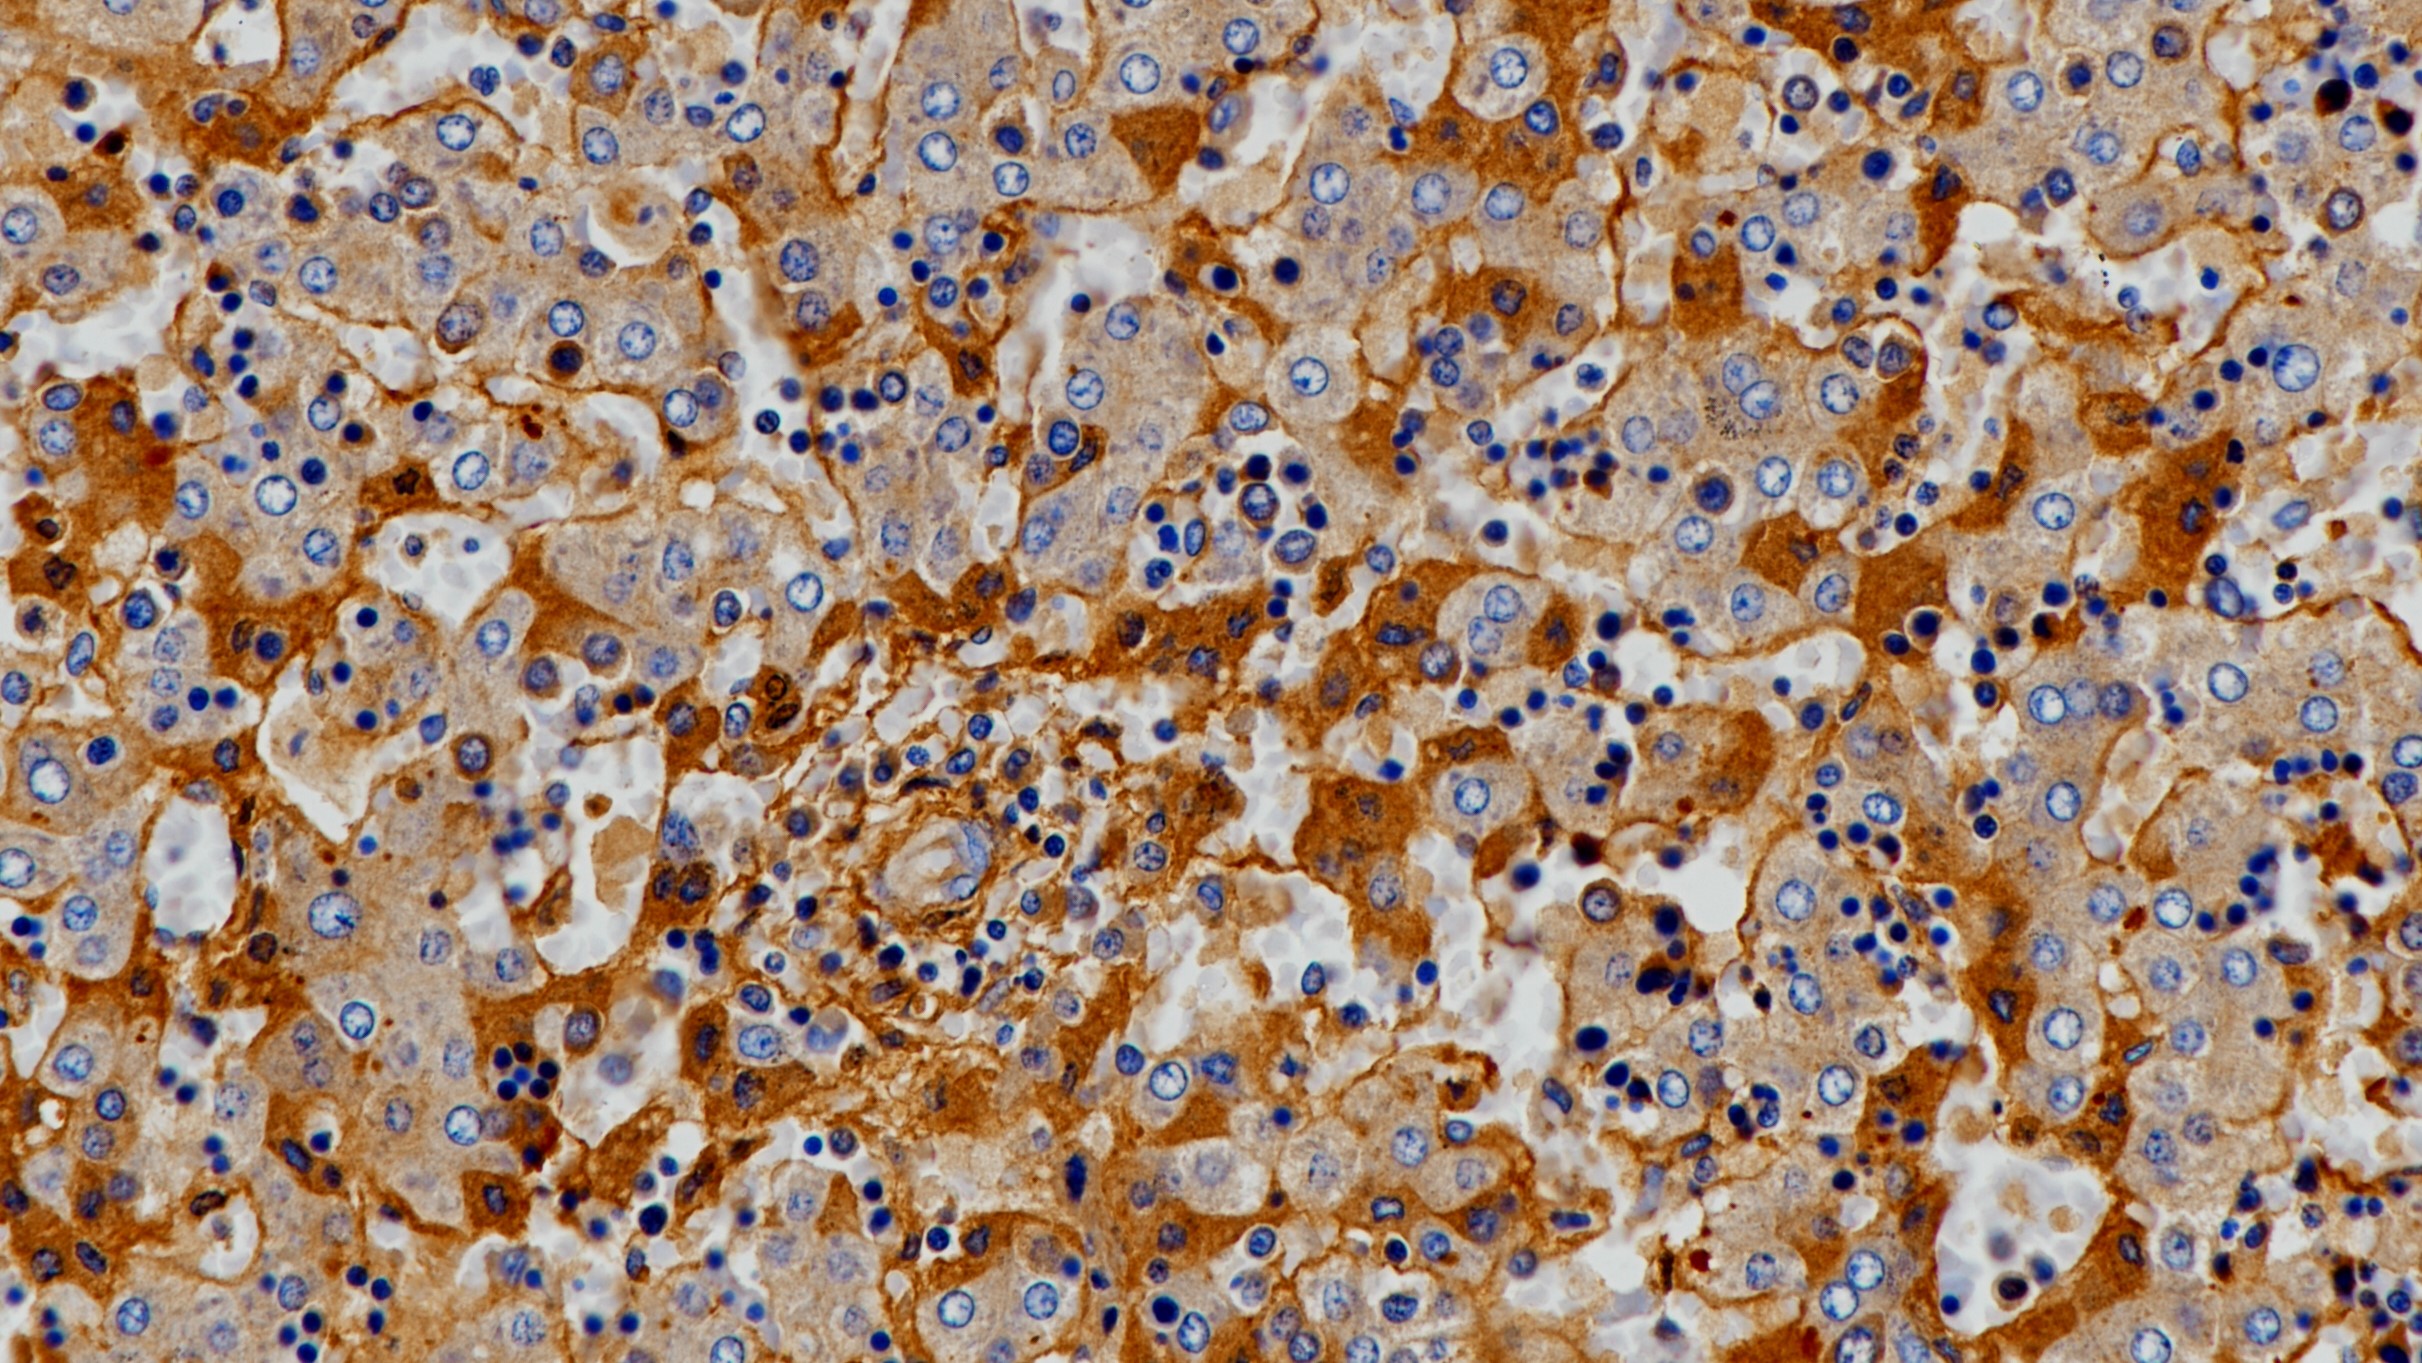
胚肝AFP(poly)染色
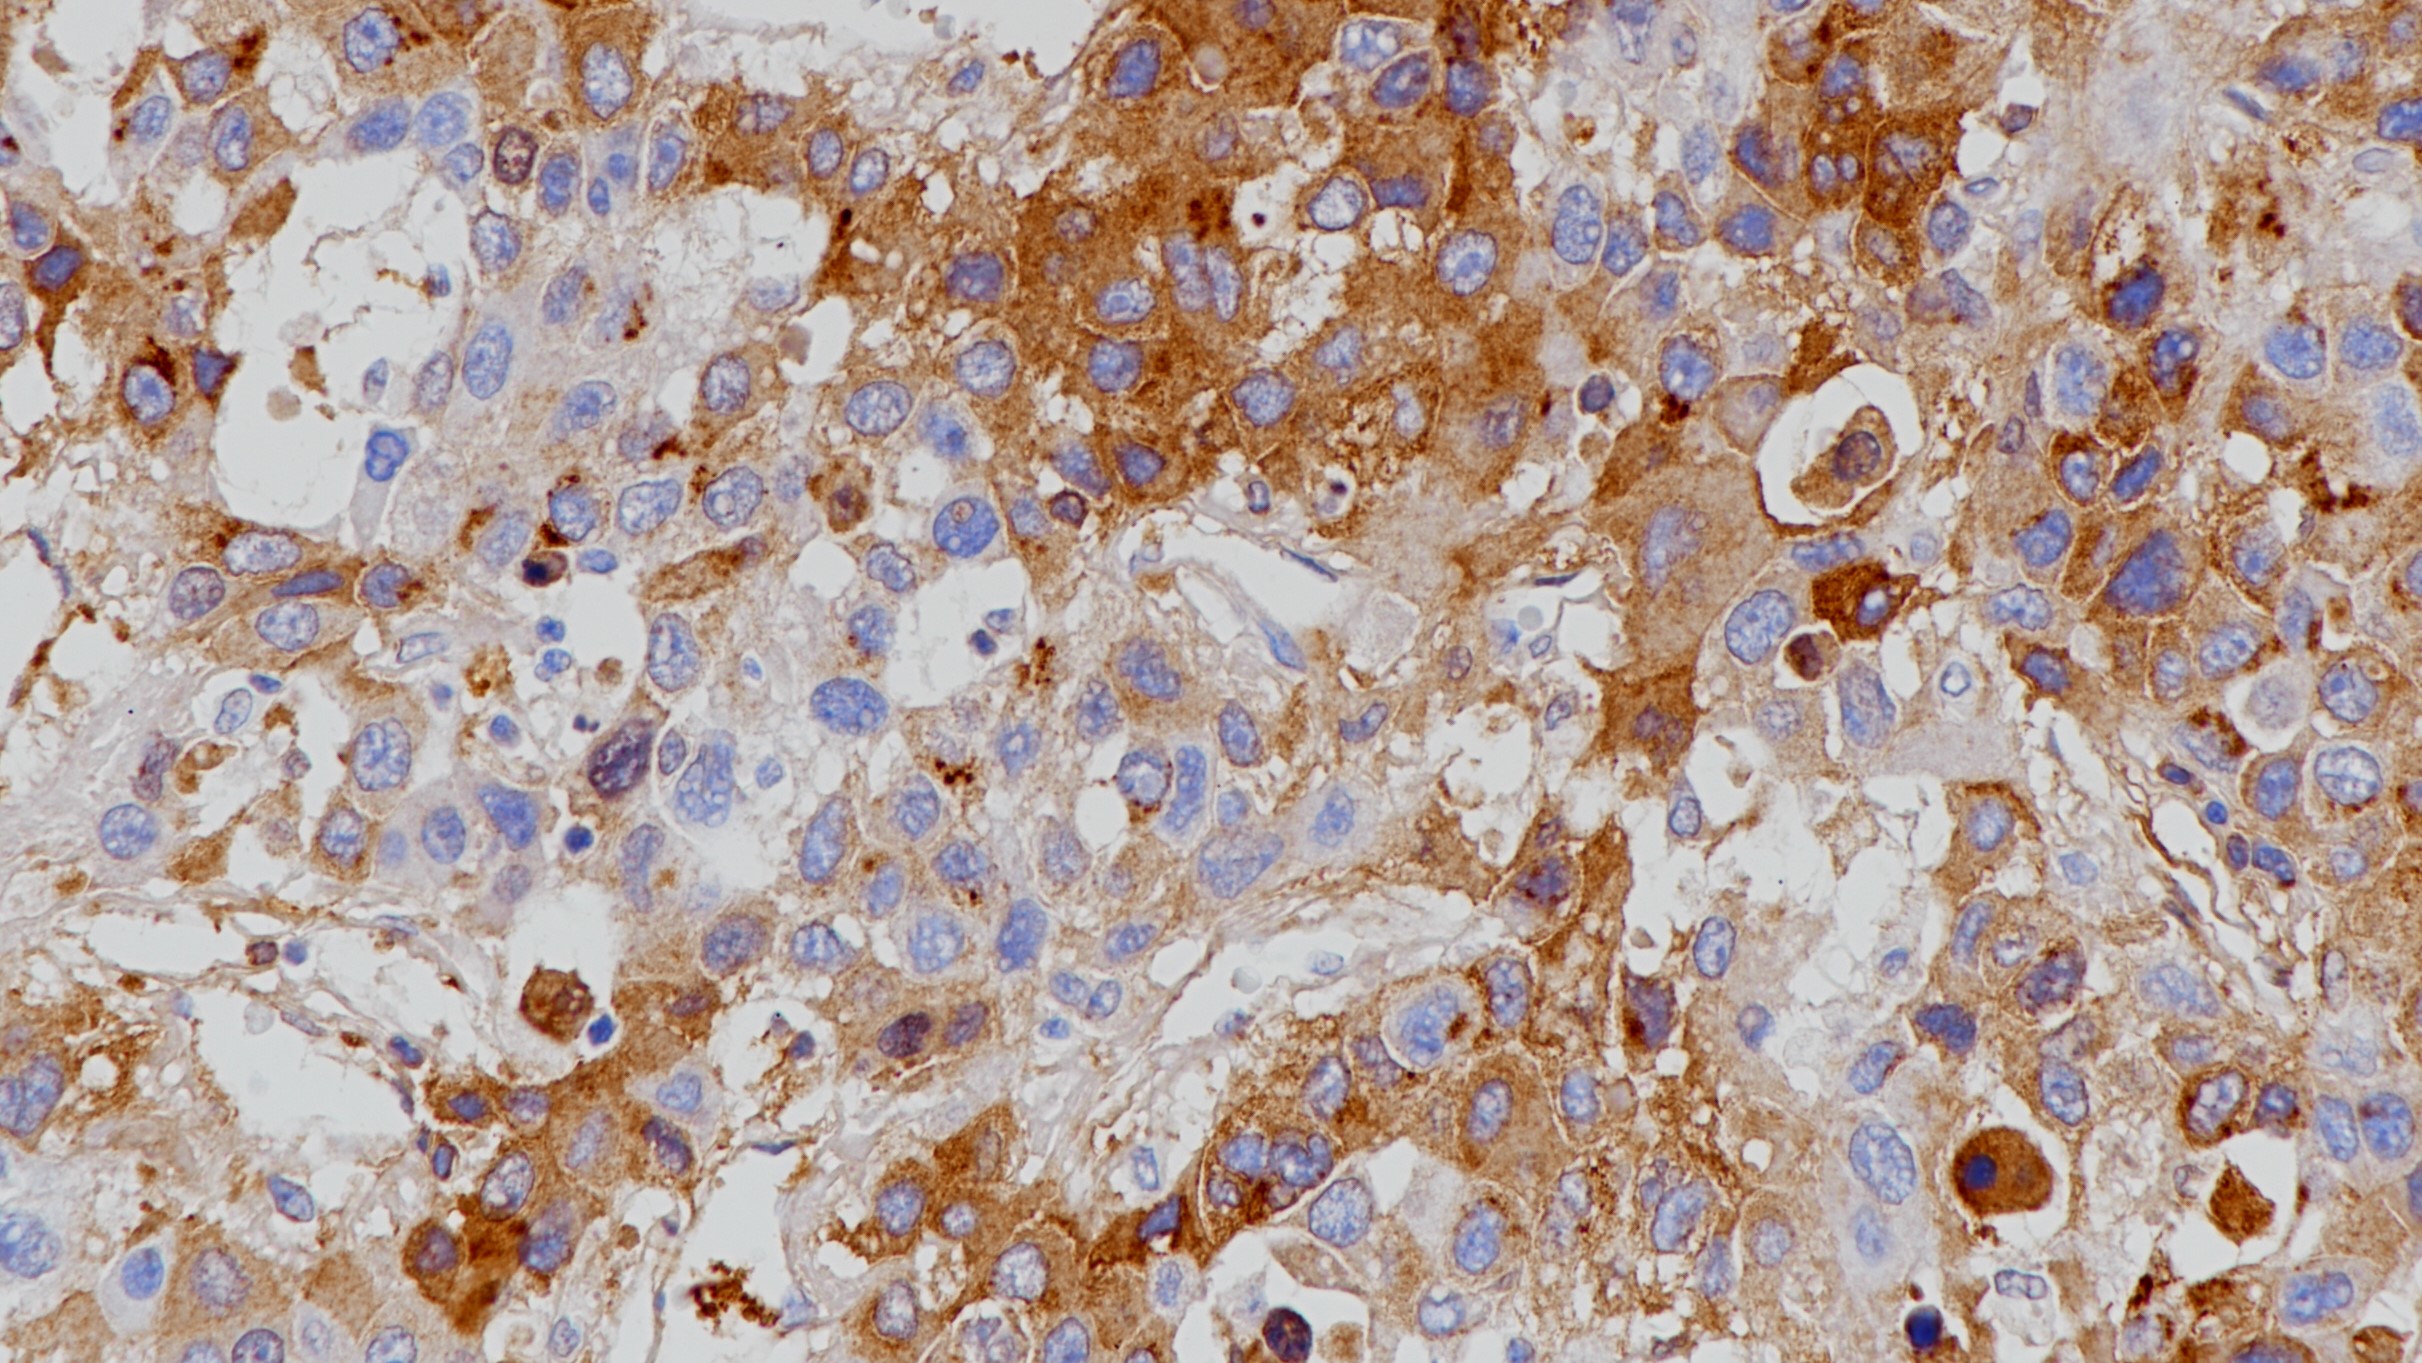
肝癌AFP(poly)染色

1.Takafumi HyodoRyuichi Kawamoto. Double cancer of the stomach, one AFP-producing tumor. J Gastroenterology 1996 NOV;31(6)851-854.
2.Scheithauer W, Chott A, Knoflach P. Alpha-fetoprotein-positive adenocarcinoma of the pancreas. Int J Pancreatol 1989 Feb;4(1):99-103.
3.中华医学会.《临床技术操作规范·病理学分册》.人民军医出版社,2004.